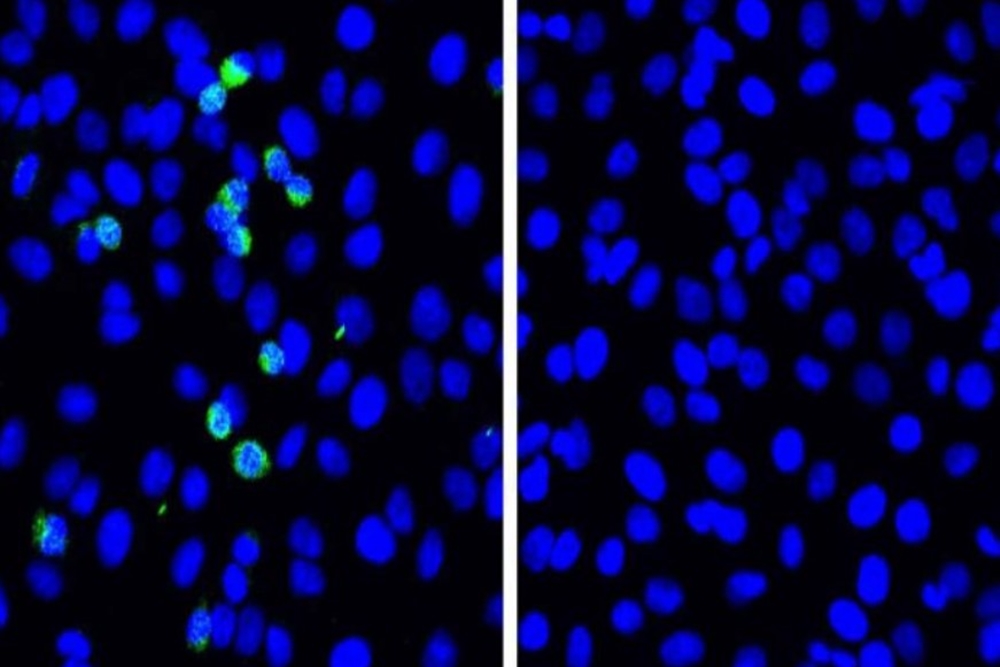

A descoberta liderada pelo professor Akinori Takaoka do Instituto de Medicina Genética, mostrou que a RIG-I, uma molécula biológica que detecta vírus de RNA, restringe a replicação do SARS-CoV-2 em células pulmonares humanas.
Uma equipe de cientistas da Universidade de Hokkaido, no Japão, identificou uma proteína que impede a replicação da Covid, ou seja, poderá conter a doença.
A descoberta liderada pelo professor Akinori Takaoka do Instituto de Medicina Genética, mostrou que a RIG-I, uma molécula biológica que detecta vírus de RNA, restringe a replicação do SARS-CoV-2 em células pulmonares humanas.
E ela pode ajudar até mesmo pacientes com doença pulmonar obstrutiva crônica- DPOC, entre elas, bronquite e enfisema, um fator de risco para a Covid-19.
A equipe registrou a descoberta em um estudo, publicado este mês no jornal Nature Immunology.
Defesa
Em outras palavras, os cientistas da Universidade de Hokkaido descobriram uma nova resposta defensiva ao SARS-CoV-2 que envolve o receptor de reconhecimento de padrão viral RIG-I.
Patógenos microbianos em nosso corpo são detectados por proteínas chamadas receptores de reconhecimento de padrões (PRRs), que também desencadeiam respostas imunológicas a esses patógenos.
As infecções virais são detectadas por um subconjunto de PRRs; os cientistas concentraram sua atenção na proteína RIG-I, que pertence a este subconjunto.
RIG-I é conhecido por ser crítico para a detecção e resposta a vírus de RNA, como o vírus da gripe.
Experimentos
Em experimentos realizados em linhas de cultura de células, os cientistas descobriram que havia pouca resposta imune inata ao SARS-CoV-2 nas células pulmonares, sugerindo que a via de sinalização que leva à resposta imune foi abortada.
No entanto, a replicação viral foi suprimida.
Os cientistas investigaram o papel do RIG-I e descobriram que sua deficiência causava um aumento na replicação viral. Outras experiências confirmaram que a supressão da replicação viral era dependente de RIG-I.
Trabalhos adicionais devem ser feitos para descobrir fatores ou condições que modulam os níveis de expressão de RIG-I e podem levar a novas estratégias para controlar a infecção por SARS-CoV-2.
Bloqueia a replicação
“Descobrimos que os níveis de proteína de RIG-I podem ser significativamente regulados de uma maneira dependente da dose após o tratamento com tretinoína nessas células derivadas de pacientes com DPOC”, explicam os pesquisadores, na pesquisa.
Os estudiosos acreditam que a RIG-I diminui a replicação do coronavírus devido a um elemento estrutural que ela carrega chamado domínio helicase.
Ele interage com o material genético do malfeitor e bloqueia uma enzima responsável por tirar “cópias” do vírus, chamada de polimerase.
Com informações da Universidade de Hokkaido/News Medical